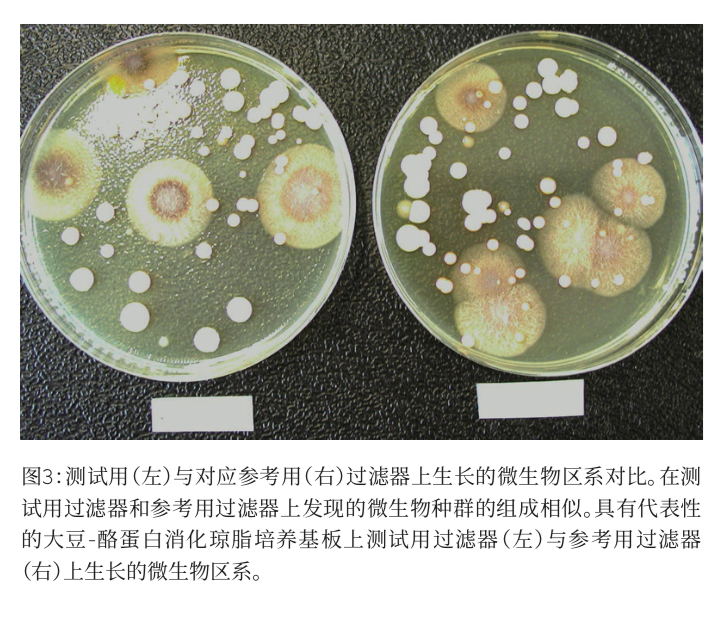
1645169327124252_6.png
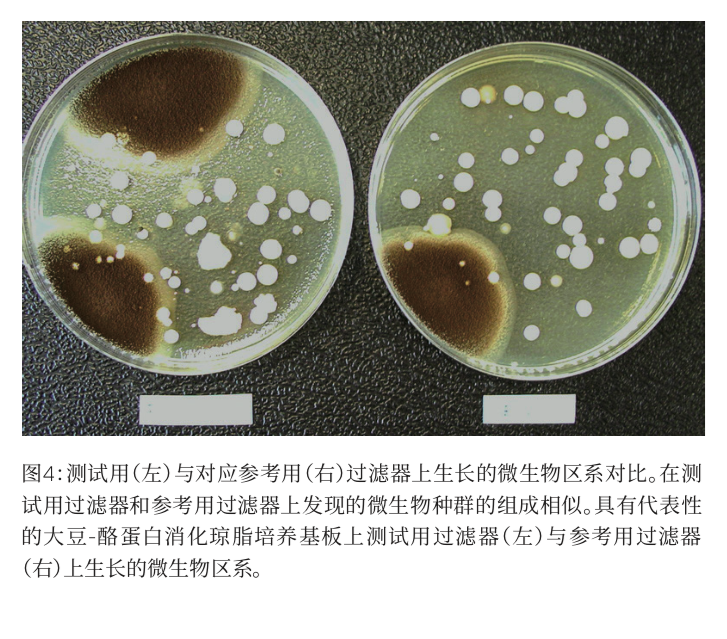
1645169328864600_7.png

公司新闻/正文
607 人阅读发布时间:2022-02-18 15:44
Overview
环境监测是无菌药品生产环境质量保证的重要环节。尤其是在没有最终灭菌步骤的无菌灌装线上,环境监测对产品安全至关重要,因此是质量控制策略的重要组成部分。
一种典型的空气污染监测方法是首先进行抽空气,然后通过特殊的凝胶过滤器过滤。凝胶膜过滤器可以持续使用8小时,从而可以避免发生更换琼脂板等人为干预,将二次污染的风险降低到几乎为零。
Download
本篇《洁净室环境中的连续微生物空气监测》应用说明采用MD8 Airscan®系统,研究了对来自层流罩空气进行高效空气过滤HEPA-filtered,凝胶过滤器在8小时过滤期间捕获的生物体的回收率和存活能力,从而证明赛多利斯的凝胶膜能在整整8小时的轮班期间连续监测药品工业化生产环境中的空气,而且不需要人工干预。

扫二维码 下载全文

简介
下列研究的目的是通过确定被捕获的生物体是否能够承受长期的干燥压力,而且还能恢复原状,证明连续取样(和多取样点试验)能否对整个生产过程(8 h)提供有效监测。
本研究采用MD8 Airscan® 系统对凝胶过滤器进行8小时连续空气取样,另外以并行运行的参考用过滤器作为参照物,对加压和未加压过滤器进行对比。通过计算CFU的数量,和确定已识别微生物种群的类属,证明了在连续长期取样期间微生物没有发生任何变化。
MD8 Airscan®

材料和方法
本研究对在过滤空气的长期过滤过程中凝胶膜上微生物是否能保持存活能力进行了研究。
首先,将测试用凝胶过滤器和参考用凝胶过滤器暴露在灭菌空气中30分钟。MD8 Airscan®空气取样器(气流速率设置为 2.0 m3/h(0,144 m/s))布置在非受控性实验室环境(高压室)中,相互间隔约 30 ~ 40 cm。该位置的相对湿度较高(~ 57 ± 6 %和温度:~ 21 ± 1 °C)。
接下来,使用测试用过滤器,对过滤空气再取样8小时。
参考用过滤器只进行30分钟的非无菌空气过滤,不再进一步通风。取样后直接将参考用过滤器置于大豆酪蛋白消化琼脂培养基上。
在层流罩下过滤8小时后,测试用过滤器也放置在大豆酪蛋白消化琼脂培养基板上,在 32 °C下培育4天。
计算产生的菌落数量,用CFU/m3 表示,共26次。然后,对比测试用过滤器和参考用过滤器的 CFU/m3。此外,为了确定微生物区系是否在长期连续取样期间发生了变化,确定了每个菌落的类属。
结果
图1显示了测试用过滤器(金色条,平均 = 69个菌落,sd = 51个菌落)和参考过滤器用(灰色条,平均 = 64个菌落,sd = 32个菌落)的平均CFU/m3。发现了5级空气中CFU/m3的平均差异(根据配对T测试,在统计学上不明显),但经对比测试用过滤器和参考用过滤器,未观察到总体变化趋势(见图2)。在12个案例中,测试用过滤器的CFU/m3 高于参考用过滤器,但13个案例的研究结果相反(见图2)。在非受控环境空气中,微生物自然存在较大的波动,这是造成测试用过滤器和参考用过滤器之间标准偏差的主要原因。


图3和图4显示了具有代表性的大豆-酪蛋白消化琼脂培养基板上配对测试用(左)和参考用(右)过滤器生长的微生物区系, 没有观察到测试用过滤器与参考用过滤器的微生物生长存在统计学上明显的差异。

图5A和图5B所示的微生物区系的宏观比较得到的属类识别数据,证实了测试用和参考用过滤器上微生物种群类似这一视觉印象。


图5A.测试用凝胶过滤器上生长的微生物种群的对比。生长在测试用过滤器上的微生物几乎均为球菌。此图显示了生长在测试用过滤器的大豆-酪蛋白消化琼脂培养基板上的微生物的分类。
图5B.参考用凝胶过滤器上生长的微生物种群的对比。生长在参考用过滤器上的微生物几乎均为球菌。此图显示了生长在参考用过滤器的大豆-酪蛋白消化琼脂培养基板上的微生物的分类。
Conclusion
实验结果表明,测试用(加压)过滤器与参考用(未加压)过滤器之间无统计学差异。测试用过滤器的CFU/m3数量与参考用过滤器相同(即,长期过滤过程中没有微生物死亡)。此外,无论是视觉比较还是宏观比较,无法检测到测试用过滤器与参考用过滤器上生长的菌群之间存在差异。加压凝胶过滤器与未加压凝胶过滤器之间没有统计学差异。
总之,本研究表明加压凝胶过滤器与未加压凝胶过滤器之间没有统计学差异,从而证明赛多利斯生产的凝胶膜能在整整8小时的轮班期间连续监测药品工业化生产环境中的空气,而且不需要人工干预。
更多详细解读 敬请下载全文